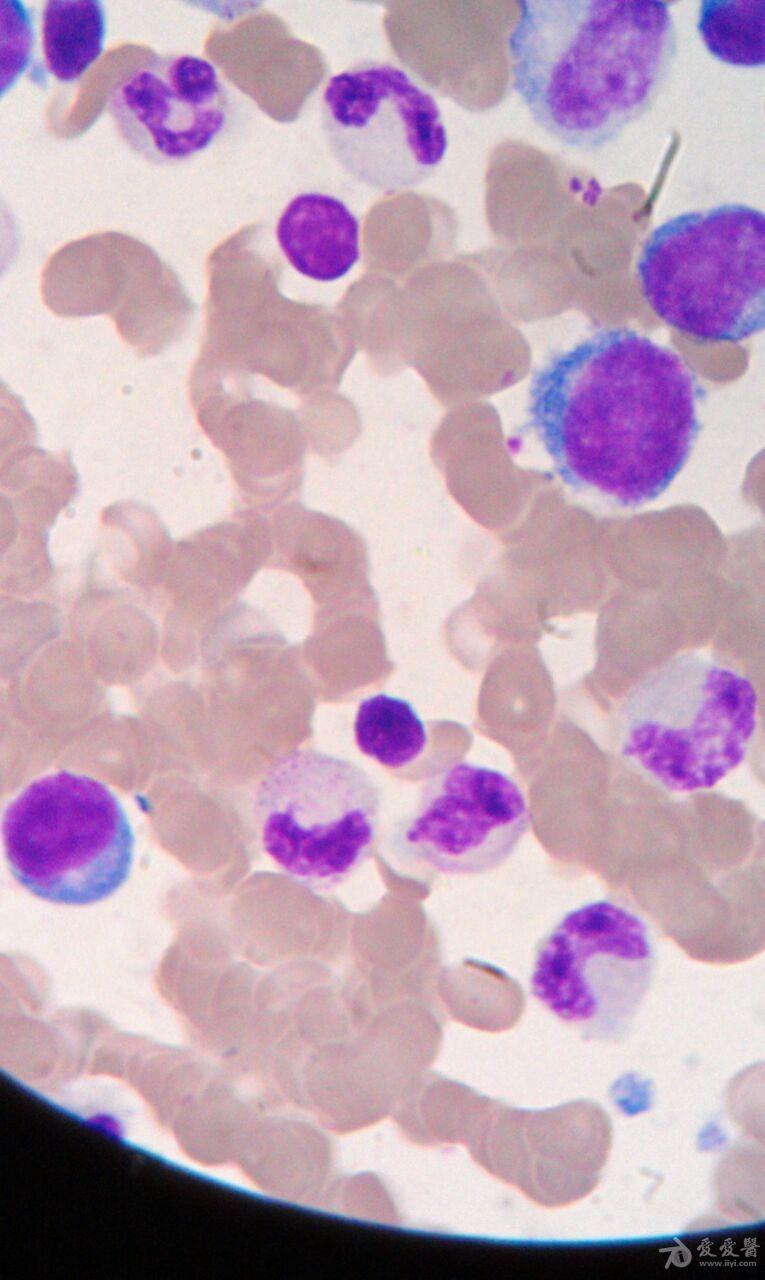
血液细胞形态学求助

细胞形态学

细胞的形态与结构
图片尺寸1263x992
血细胞形态学之原始细胞
图片尺寸1080x2412
图2-1 细胞的形态和种类
图片尺寸830x533
2018年细胞形态学培训考试
图片尺寸2103x1920
显微镜下的尿液中和白带中能看到什么快来看看吧!#细胞形态学 - 抖音
图片尺寸1183x903
收藏 | 常见骨髓细胞形态图谱
图片尺寸650x484
犬猫细胞学的正常细胞形态鉴定指南
图片尺寸863x1282
2018年细胞形态学培训考试
图片尺寸2578x1768
形态学学习第三期浆细胞
图片尺寸825x608
每种细胞总是保持一定的形态
图片尺寸771x728
动物细胞的生物化学形态
图片尺寸802x720
2018年细胞形态学培训考试
图片尺寸2494x1747
细胞的形态与结构
图片尺寸1649x809
血细胞形态图片doc
图片尺寸920x1302
【检验】形态学图谱②Ⅱ白细胞形态学图谱
图片尺寸1013x1280
涂抹细胞对白细胞分类的影响及其在形态学诊断中的作用
图片尺寸427x350
血细胞显微镜下形态
图片尺寸1004x654
秀山医学检验质量控制中心"金显微镜"形态学培训(第45期)
图片尺寸2540x1933
正常血细胞形态学(1)
图片尺寸1080x810
血液细胞形态学求助
图片尺寸765x1280